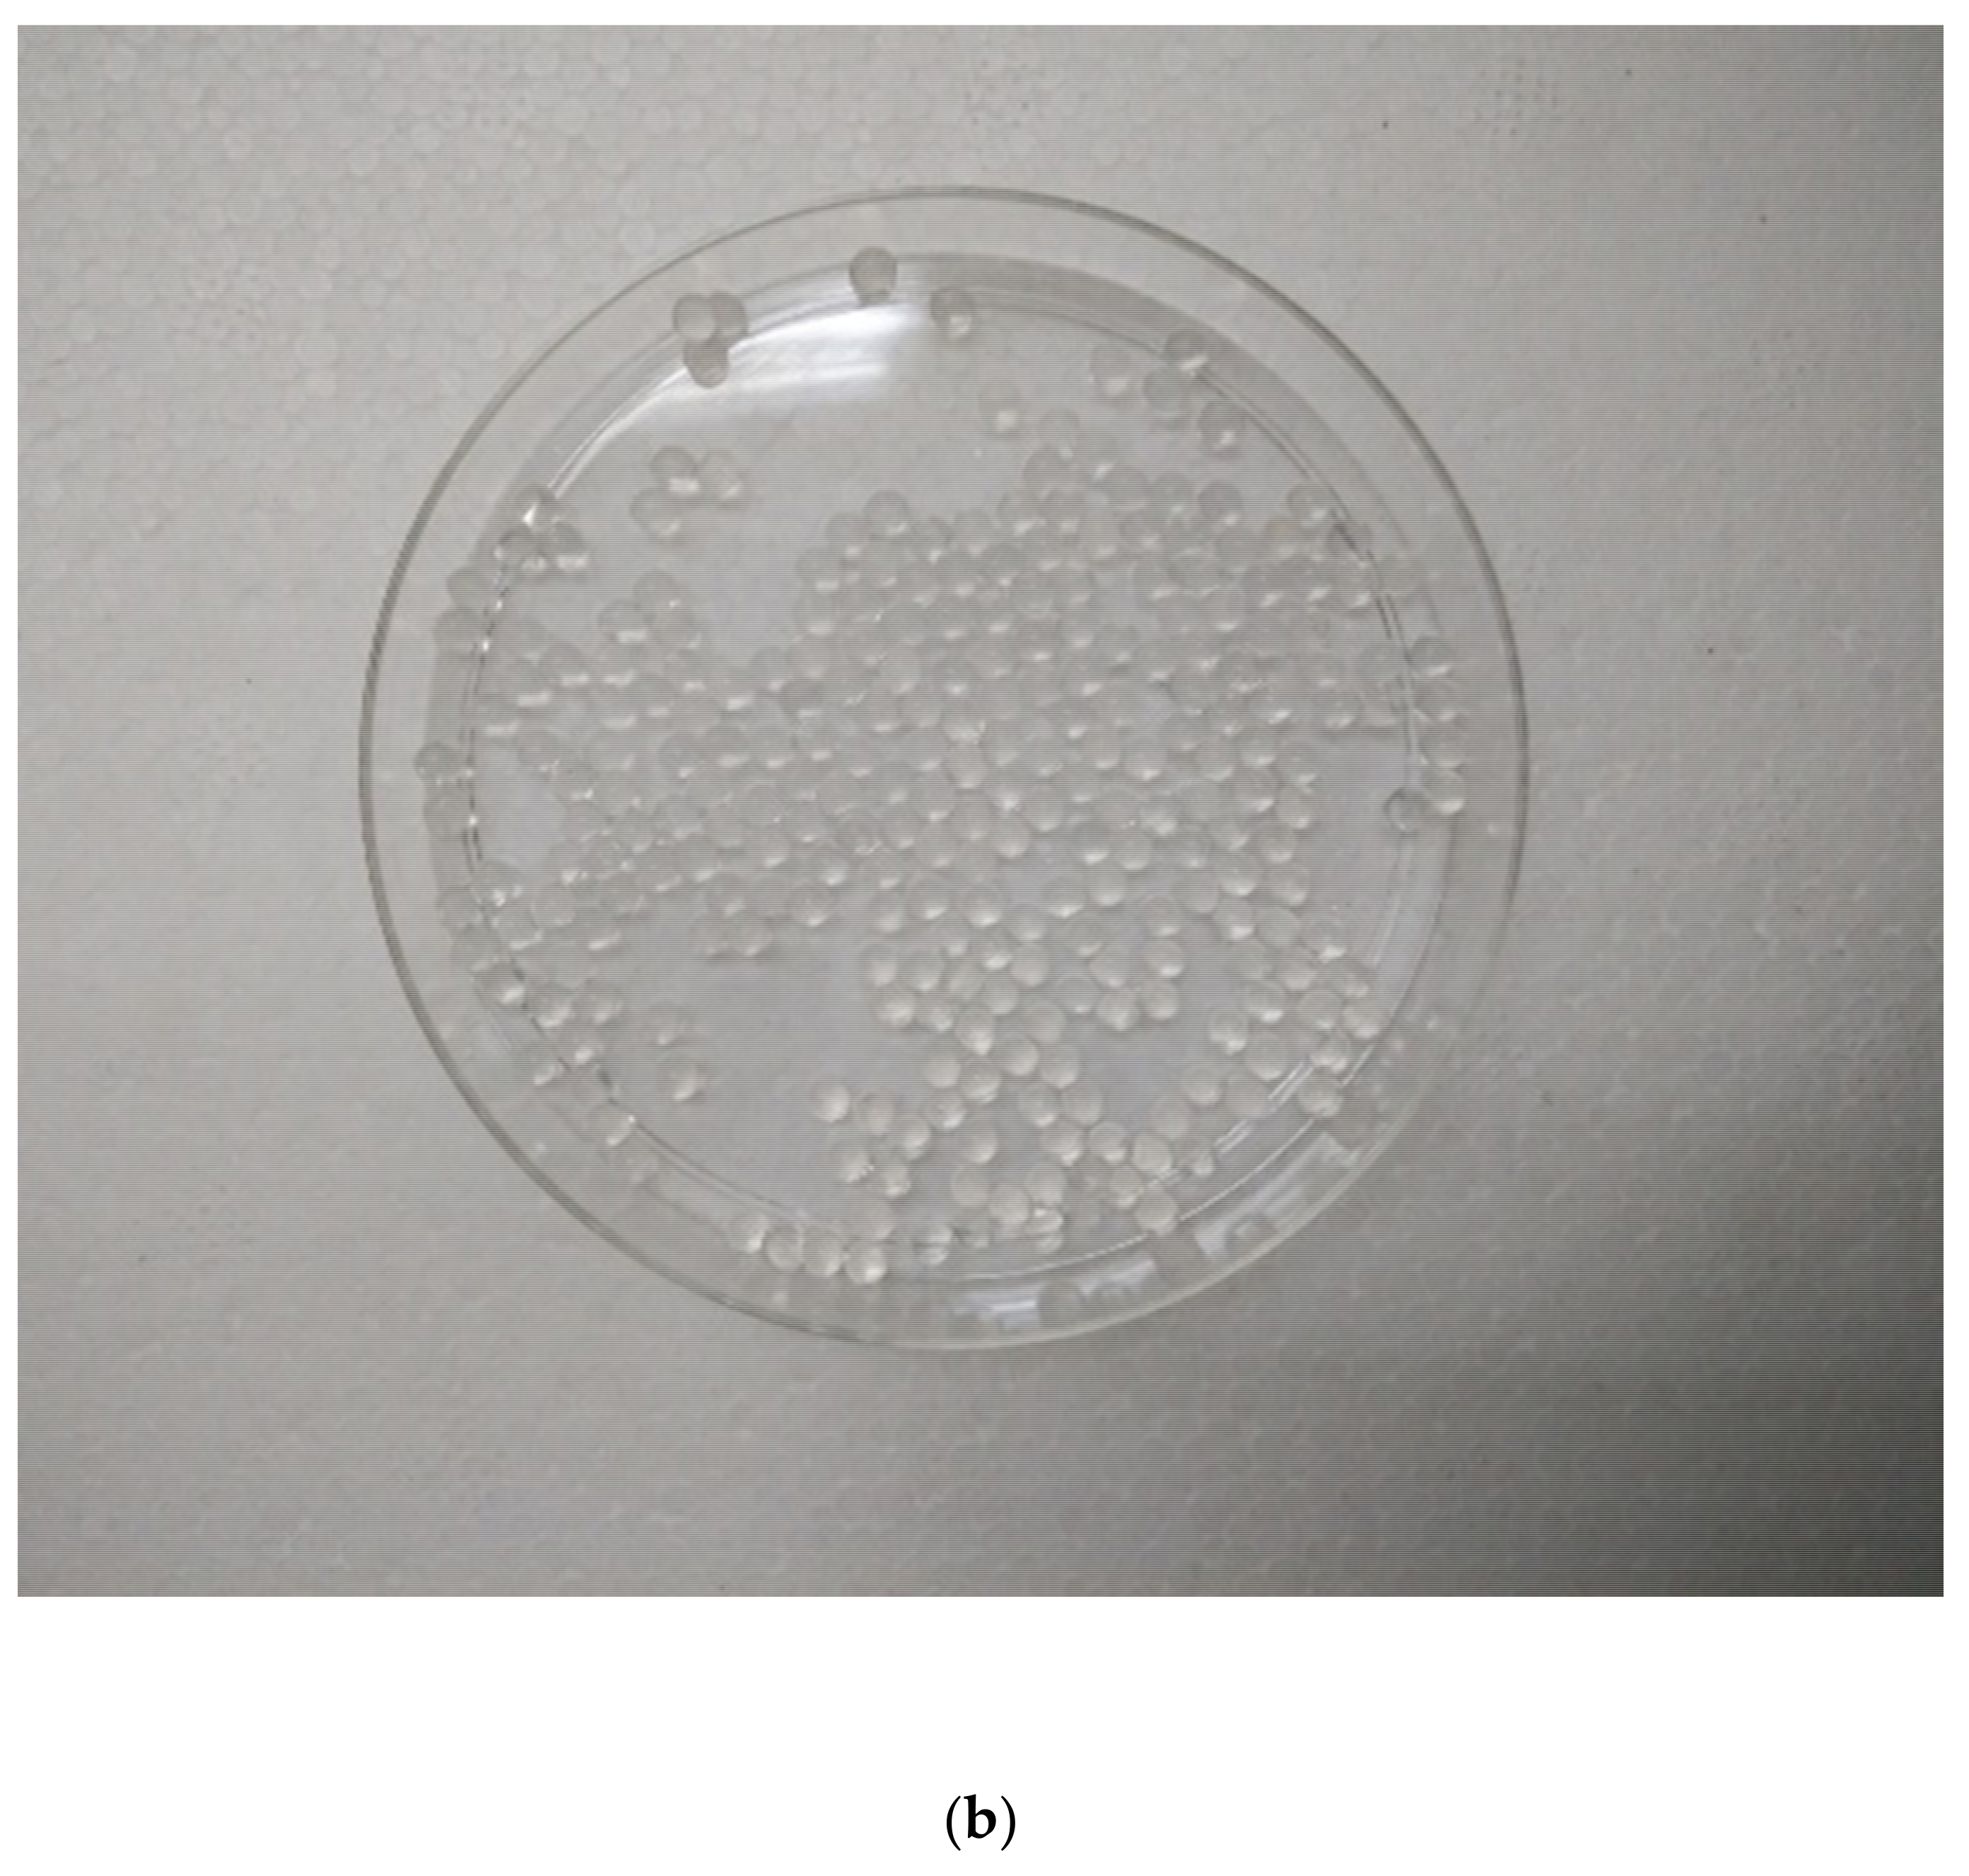
Sustainability 13 11562 g003b

Post-Treatment of Palm Oil Mill Effluent Using Immobilised Green Microalgae Chlorococcum oleofaciens
Abstract
:1. Introduction
2. Materials and Methods
2.1. Sampling of POME
2.2. Algae Culture Media
2.3. Isolation and Cultivation of Green Microalgae
2.4. Morphological Identification of Microalgae
Microalgae Sample Processing Using HMDS Method
2.5. Molecular Identification of Algal Strain
2.6. Green Microalgae–Alginate Beads Preparation
2.7. Experimental Setup
2.8. Analytical Methods
2.8.1. Measurement of Substrate Reduction
2.8.2. Chlorophyll-a Extraction and Quantification
2.8.3. Growth Rate Study
2.8.4. Growth Kinetic Study
2.8.5. Quantification of Substrate Consumption Rate
3. Results and Discussion
3.1. Identification of Green Microalgae
3.2. Selection of the Suitable Beads
3.3. Growth Study of Immobilised C. oleofaciens in LABT-POME
3.4. Removal of TP from LABT-POME
3.5. Removal of Ammonia Nitrogen and TN from LABT-POME
3.6. Reduction of Soluble COD (SCOD) from LABT-POME
4. Conclusions
Author Contributions
Funding
Institutional Review Board Statement
Informed Consent Statement
Data Availability Statement
Acknowledgments
Conflicts of Interest
References
- Parthasarathy, S.; Mohammed, R.R.; Fong, C.M.; Gomes, R.L.; Manickam, S. A novel hybrid approach of activated carbon and ultrasound cavitation for the intensification of palm oil mill effluent (POME) polishing. J. Clean. Prod. 2016, 112, 1218–1226. [Google Scholar] [CrossRef] [Green Version]
- Ahmad, A.; Buang, A.; Bhat, A.H. Renewable and sustainable bioenergy production from microalgal co-cultivation with palm oil mill effluent (POME): A review. Renew. Sustain. Energy Rev. 2016, 65, 214–234. [Google Scholar] [CrossRef]
- EQA. Environmental Quality Act (Prescribed Premises) (Crude Palm Oil) Regulations; Department of Environment: Putrajaya, Malaysia, 1974; Volume 93. [Google Scholar]
- Emparan, Q.; Jye, Y.S.; Danquah, M.K.; Harun, R. Cultivation of Nannochloropsis sp. microalgae in palm oil mill effluent (POME) media for phycoremediation and biomass production: Effect of microalgae cells with and without beads. J. Water Process. Eng. 2020, 33, 101043. [Google Scholar]
- Zulfahmi, I.; Ravika, N.; Feizia, H.; Lina, R.; Muliari, M.; Kizar, A.S.; Mohammad, M.R. Phytoremediation of Palm Oil Mill Effluent (POME) Using Water Spinach (Ipomoea Aquatica Forsk). Environ. Technol. Innov. 2021, 21, 101260. [Google Scholar] [CrossRef]
- Ahmad, A.; Krimly, M.Z. Palm oil mill effluent treatment process evaluation and fate of priority components in an open and closed digestion system. Curr. World Environ. 2014, 9, 321–330. [Google Scholar] [CrossRef] [Green Version]
- Wu, T.Y.; Mohammad, A.W.; Jahim, J.M.; Anuar, N. Pollution control technologies for the treatment of palm oil mill effluent (POME) through end-of-pipe processes. J. Environ. Manag. 2010, 91, 1467–1490. [Google Scholar] [CrossRef]
- Delrue, F.; Álvarez-Díaz, P.D.; Fon-Sing, S.; Fleury, G.; Sassi, J.-F. The Environmental Biorefinery: Using Microalgae to Remediate Wastewater, a Win-Win Paradigm. Energies 2016, 9, 132. [Google Scholar] [CrossRef]
- Goswami, R.K.; Mehariya, S.; Verma, P.; Lavecchia, R.; Zuorro, A. Microalgae-based biorefineries for sustainable resource recovery from wastewater. J. Water Process. Eng. 2021, 40, 101747. [Google Scholar] [CrossRef]
- Mehariya, S.; Fratini, F.; Lavecchia, R.; Zuorro, A. Green extraction of value-added compounds form microalgae: A short review on natural deep eutectic solvents (NaDES) and related pre-treatments. J. Environ. Chem. Eng. 2021, 9, 105989. [Google Scholar] [CrossRef]
- Ding, G.T.; Yaakob, Z.; Takkriff, M.S.; Salihon, J.; Rahaman, M.S.A. Biomass production and nutrients removal by a newly-isolated microalgal strain Chlamydomonas sp in palm oil mill effluent (POME). Int. J. Hydrogen Energy 2016, 41, 4888–4895. [Google Scholar] [CrossRef]
- Khalid, A.A.H.; Yaakob, Z.; Abdullah, S.R.S.; Takriff, M.S. Growth improvement and metabolic profiling of native and commercial Chlorella sorokiniana strains acclimatised in recycled agricultural wastewater. Bioresour. Technol. 2016, 247, 930–939. [Google Scholar] [CrossRef]
- Nur, M.M.A.; Setyoningrum, T.M.; Budiaman, I.G.S. Potency of Botryococcus braunii cultivated on palm oil mill effluent (POME) wastewater as the source of biofuel. Environ. Eng. Res. 2018, 22, 1–8. [Google Scholar]
- Babu, A.; Katam, K.; Gundupalli, M.P.; Bhattacharyya, D. Nutrient removal from wastewater using microalgae: A kinetic evaluation and lipid analysis. Water Environ. Res. 2018, 90, 520–529. [Google Scholar] [CrossRef]
- Kayombo, S.; Mbwette, T.S.A.; Katima, J.H.Y.; Jorgensen, S.E. Effects of substrate concentrations on the growth of heterotrophic bacteria and algae in secondary facultative ponds. Water Res. 2003, 37, 2937–2943. [Google Scholar] [CrossRef]
- Sanchez-Galvis, E.M.; Cardenas-Gutierrez, I.Y.; Contreras-Ropero, J.E.; Garcia-Martinez, J.B.; Barajas-Solano, A.F.; Zuorro, A. An innovative low-cost equipment for electro-concentration of microalgal biomass. Appl.Sci. 2020, 10, 4841. [Google Scholar] [CrossRef]
- Richmond, A. Handbook of Microalgal Culture: Biotechnology and Applied Phycology; John Wiley & Sons: Hoboken, NJ, USA, 2008. [Google Scholar]
- Bellinger, E.G.; Sigee, D.C. Freshwater Algae: Identification, Enumeration and Use as Bioindicators; John Wiley & Sons. Ltd.: Chichester, UK, 2015. [Google Scholar]
- Glauert, A.M. Fixation, Dehydration and Embedding of Biological Specimens. In Practical Methods in Electron Microscopy; Elsevier Science: Amsterdam, The Netherlands, 1984. [Google Scholar]
- Fiera, C. Detection of food in the gut content of Heteromurusnitidus (Hexapoda:Collembola) by DNA/PCR-based molecular analysis. North-West. J. Zool. 2014, 10, 67–73. [Google Scholar]
- Ruiz-Güereca, D.A.; Sánchez-Saavedra, M.d.P. Growth and phosphorus removal by Synechococcus elongatus co-immobilized in alginate beads with Azospirillum brasilense. J. Appl. Phycol. 2016, 28, 1501–1507. [Google Scholar] [CrossRef]
- Ritchie, R.J. Consistent Sets of Spectrophotometric Chlorophyll Equations for Acetone, Methanol and Ethanol Solvents. Photosynth. Res. 2006, 89, 27–41. [Google Scholar] [CrossRef] [PubMed]
- Delgadillo-Mirquez, L.; Lopes, F.; Taidi, B.; Pareau, D. Nitrogen and phosphate removal from wastewater with a mixed microalgae and bacteria culture. Biotechnol. Rep. 2016, 11, 18–26. [Google Scholar] [CrossRef]
- Ermis, H.; Altınbaş, M. Determination of biokinetic coefficients for nutrient removal from anaerobic liquid digestate by mixed microalgae. Environ. Boil. Fishes 2018, 31, 1773–1781. [Google Scholar] [CrossRef]
- Peleg, M.; Corradini, M.; Normand, M.D. The logistic (Verhulst) model for sigmoid microbial growth curves revisited. Food Res. Int. 2007, 40, 808–818. [Google Scholar] [CrossRef]
- Banerjee, S.; Balakdas Tiwade, P.; Sambhav, K.; Banerjee, C.; Kumar Bhaumik, S. Effect of alginate concentration in wastewater nutrient removal using alginate-immobilised microalgae beads: Uptake kinetics and adsorption studies. Biochem. Eng. J. 2019, 149, 1–12. [Google Scholar] [CrossRef]
- de-Bashan, L.E.; Bashan, Y. Immobilised microalgae for removing pollutants: Review of practical aspects. Bioresour. Technol. 2010, 101, 1611–1627. [Google Scholar] [CrossRef]
- Aguilar-May, B.; del Pilar Sánchez-Saavedra, M.; Lizardi, J.; Voltolina, D. Growth of Synechococcus sp. immobilised in chitosan with different times of contact with NaOH. J. Appl. Phycol. 2007, 19, 181–183. [Google Scholar]
- Bajpai, S.; Sharma, S. Investigation of swelling/degradation behaviour of alginate beads crosslinked with Ca2+ and Ba2+ ions. React. Funct. Polym. 2004, 59, 129–140. [Google Scholar] [CrossRef]
- Liu, K.; Li, J.; Qiao, H.; Lin, A.; Wang, G. Immobilisation of Chlorella sorokiniana GXNN 01 in alginate for removal of N and P from synthetic wastewater. Bioresour. Technol. 2012, 114, 26–32. [Google Scholar] [CrossRef] [PubMed]
- Azlin Suhaida, A.; Nurain Atikah Che, A.; Noor Illi Mohamad, P.; Amanatuzzakiah Abdul, H.; Faridah, Y.; Suzana, Y. Chlorella vulgaris logistic growth kinetics model in high concentrations of aqueous ammonia. IIUM Eng. J. 2018, 19, 1–9. [Google Scholar]

| Reagent A | per 400 mL |
| NaNO3 | 10.00 g |
| MgSO4.7H2O | 3.00 g |
| K2HPO4 | 4.00 g |
| NaCl | 1.00 g |
| KH2PO4 | 6.00 g |
| CaCl2 | 1.00 g |
| Microelement Stock Solution * | Per 1 L |
| ZnSO4 | 8.82 g |
| MoO3 | 0.71 g |
| Co(NO3)2.6H2O | 0.49 g |
| MnCl2 | 1.44 g |
| CuSO4.5H2O | 1.57 g |
| Solution 1 | per 100 mL |
| H3BO4 | 1.14 g |
| Solution 2 | per 100 mL |
| EDTA.Na2 | 5.00 g |
| KOH | 3.10 g |
| Solution 3 | per 100 mL |
| FeSO4.7H2O | 4.98 g |
| HCl (Concentrated) | 1.00 mL |
| Target Gene | Primer (5′ → 3) | Protocol | Reference |
|---|---|---|---|
| Chloroccocum | Forward primer CLO-GEN-S3 (GCATGGAATMRCACGATAGGACTC) Reverse primer CLO-GEN-A4 (CGGCATCGTTTATGGTTGGTTGAGACTAC) | Initial: 15 min (95 °C) Denaturation: 30 s (94 °C) Annealing: 90 s (63 °C) Extension: 90 s (72 °C) Elongation: 10 min (72 °C) Total runs: 35 cycles | [20] |
| Microscopic Image (40× Magnification) | SEM Image | Cell Size (μm) | Visible Characteristics | Possible Genus |
|---|---|---|---|---|
![]() | ![]() | 10–12 | green in colour, sphere-shaped cells, contain numerous sac-like organelles | Chlorococcum sp. |
| NCBI BLAST System Result | The most Possible Species |
|---|---|
![]() | C. oleofaciens |
| Microalgae–Alginate:CaCl2 (% conc.:% conc.) | Initial Diameter of Beads (mm) | Diameter of Beads after 10 Days (mm) | Initial Chlorophyll-a (μg/mL) | Chlorophyll-a after 10 Days (μg/mL) |
|---|---|---|---|---|
| 2:2 | 3.5 ± 0.05 | 1.2 ± 0.03 | 0.501 | 5.881 |
| 2:4 | 3.3 ± 0.05 | 1.8 ± 0.05 | 0.493 | 5.679 |
| 2:6 | 3.5 ± 0.03 | 2.0 ± 0.07 | 0.512 | 5.654 |
| 4:2 | 3.3 ± 0.05 | 2.5 ± 0.08 | 0.502 | 5.021 |
| 4:4 | 3.4 ± 0.02 | 3.0 ± 0.06 | 0.495 | 4.978 |
| 4:6 | 3.5 ± 0.02 | 3.1 ± 0.02 | 0.522 | 4.889 |
| 6:2 | 3.3 ± 0.03 | 3.1 ± 0.09 | 0.506 | 2.899 |
| 6:4 | 3.4 ± 0.04 | 3.3 ± 0.01 | 0.483 | 2.333 |
| 6:6 | 3.5 ± 0.01 | 3.4 ± 0.01 | 0.517 | 2.309 |
| Microalgae | Xo (μg/mL) | Xm (μg/mL) | μ (d−1) | r2 | p-Value |
|---|---|---|---|---|---|
| Immobilised C. oleofaciens | 0.7034 | 36.9460 | 0.4867 | 0.9887 | <0.0001 |
Publisher’s Note: MDPI stays neutral with regard to jurisdictional claims in published maps and institutional affiliations. |
© 2021 by the authors. Licensee MDPI, Basel, Switzerland. This article is an open access article distributed under the terms and conditions of the Creative Commons Attribution (CC BY) license (https://creativecommons.org/licenses/by/4.0/).
Share and Cite
Tan, K.A.; Lalung, J.; Morad, N.; Ismail, N.; Wan Omar, W.M.; Khan, M.A.; Sillanpää, M.; Rafatullah, M. Post-Treatment of Palm Oil Mill Effluent Using Immobilised Green Microalgae Chlorococcum oleofaciens. Sustainability 2021, 13, 11562. https://doi.org/10.3390/su132111562
Tan KA, Lalung J, Morad N, Ismail N, Wan Omar WM, Khan MA, Sillanpää M, Rafatullah M. Post-Treatment of Palm Oil Mill Effluent Using Immobilised Green Microalgae Chlorococcum oleofaciens. Sustainability. 2021; 13(21):11562. https://doi.org/10.3390/su132111562
Chicago/Turabian StyleTan, Kah Aik, Japareng Lalung, Norhashimah Morad, Norli Ismail, Wan Maznah Wan Omar, Moonis Ali Khan, Mika Sillanpää, and Mohd Rafatullah. 2021. "Post-Treatment of Palm Oil Mill Effluent Using Immobilised Green Microalgae Chlorococcum oleofaciens" Sustainability 13, no. 21: 11562. https://doi.org/10.3390/su132111562
APA StyleTan, K. A., Lalung, J., Morad, N., Ismail, N., Wan Omar, W. M., Khan, M. A., Sillanpää, M., & Rafatullah, M. (2021). Post-Treatment of Palm Oil Mill Effluent Using Immobilised Green Microalgae Chlorococcum oleofaciens. Sustainability, 13(21), 11562. https://doi.org/10.3390/su132111562




